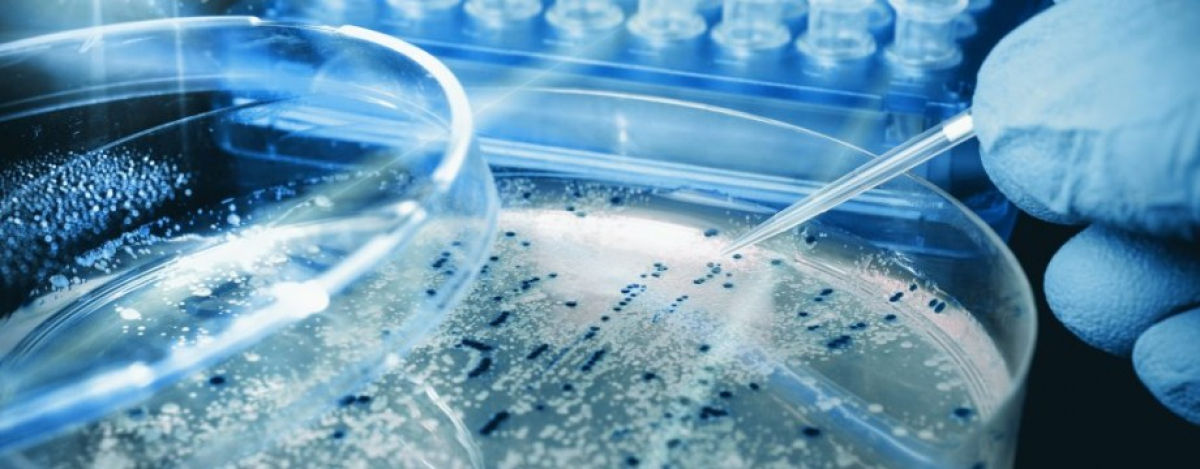

- A-
- A
- A+
Gənc alim: Dövlət dəstəyi, qrant proqramları gənc alimləri tədqiqatlar aparmağa həvəsləndirir

Fidan Qüdrətova Elm və Təhsil Nazirliyinin Molekulyar Biologiya İnstitutunda elmi işçi kimi fəaliyyət göstərən gənc tədqiqatçıdır. O, molekulyar biologiya sahəsində apardığı araşdırmalarla fərqlənən alimlərdəndir. AzərTac-ın müxbiri onunla elmi fəaliyyəti, tədqiqat istiqamətləri və gələcək planları barədə söhbətləşib. Müsahibəni təqdim edirik.
- Fidan xanım, molekulyar biologiya və biofizikanı seçməyinizə səbəb nə oldu və hazırda institutda hansı tədqiqat istiqamətləri üzrə çalışırsınız?
- Molekulyar biologiya və biofizikanı seçməyimin əsas səbəbi bu sahələrin xərçəng xəstəliklərinin hüceyrə və molekulyar mexanizmlərini araşdırmaq üçün əsas elmi istiqamət olması və fundamental biologiya ilə tibbi tətbiqlər arasında körpü rolu oynamasıdır.
İnstitutda çalışmağa elmi maraqlarımın laboratoriyanın tədqiqat istiqamətləri ilə üst-üstə düşməsi nəticəsində başlamışam. Molekulyar hüceyrə biokimyası və siqnalların ötürülməsi laboratoriyasında əsas diqqətimiz hüceyrədaxili siqnal mexanizmlərinin, xüsusilə, böyük kalium (BK) ion kanallarının öyrənilməsinə yönəlib. Xərçəngin inkişafında hüceyrədaxili siqnal ötürülməsi, ion kanallarının fəaliyyəti və oksidativ stres mühüm rol oynayır. Tədqiqatlarımız çərçivəsində zülalların ekspressiyası və təmizlənməsi, enzimatik aktivliyin ölçülməsi, spektrofotometrik və flüoresan analizlər, eləcə də bioinformatik və biokimyəvi yanaşmalardan istifadə edirik.
- “İlin alimi - 2025” müsabiqəsində “Gənc alim və tədqiqatçılar (35 yaşadək)” nominasiyası üzrə qalib olmusunuz. Müsabiqə necə keçdi? Elmi işinizdə hansı məqamlara xüsusi diqqət yetirildi?
- Müsabiqə çoxmərhələli və obyektiv qiymətləndirmə prosesi ilə yadda qaldı. Elmi işimin yenilik dərəcəsi, metodoloji əsaslandırılması, nəticələrin elmi və praktik əhəmiyyəti əsas meyarlardan idi. Xüsusilə, “Big Potassium” kanallarının yalnız ion keçiricisi kimi deyil, eyni zamanda, peroksidaza bənzər aktivliyə malik funksional zülal kimi təqdim olunması maraq doğurdu. Bu yanaşma ion kanallarına klassik baxışdan kənara çıxan yeni konseptual çərçivə təklif edir. Məqaləmizin dərc olunduğu “International Journal of Molecular Sciences” (IJMS) jurnalı molekulyar biologiya, biokimya, molekulyar tibb və əlaqəli sahələri əhatə edən elmi jurnaldır və MDPI nəşriyyatına aiddir.
-Gələcək tədqiqat planlarınız nələrdir?
- Əsas məqsədlərimdən biri BK kanalının enzimatik fəallığının molekulyar mexanizmlərini daha dərindən araşdırmaqdır. Bu istiqamətdə artıq bir sıra yeni çap olunmuş və çap mərhələsində olan elmi əsərlərimiz də var. Bununla yanaşı, bu funksiyanın xərçəng və neyrodegenerativ xəstəlik modellərində rolunu öyrənməyi planlaşdırırıq.
-Sizcə, Azərbaycanda gənc alimlər üçün elm sahəsində çalışmağın hansı çətinlikləri və üstünlükləri var?
- Fikrimcə, maddi-texniki bazanın və maliyyə imkanlarının təkmilləşdirilməsinə ehtiyac var. Bəzən beynəlxalq əməkdaşlığa çıxış da çətin olur. Lakin üstünlüklər də az deyil, dövlət dəstəyi, qrant proqramları və elmi müsabiqələr gənc alimlər üçün böyük motivasiya yaradır.
-Gənc tədqiqatçılara hansı məsləhətləri verərdiniz? Beynəlxalq jurnallarda dərc olunmaq və yüksəksəviyyəli tədqiqat aparmaq üçün nələrə diqqət yetirməlidirlər?
- Ən vacib məsləhətim səbirli və ardıcıl olmalarıdır. Güclü elmi nəticə qısa müddətdə deyil, davamlı zəhmət nəticəsində formalaşır. Beynəlxalq jurnallarda dərc üçün mövzunun aktuallığı və yenilik dəyəri, düzgün eksperimental dizayn, nəticələrin aydın təqdimatı, eləcə də elmi yazı bacarığı həlledici rol oynayır. Bundan əlavə, beynəlxalq ədəbiyyatı mütəmadi izləmək, konfranslarda iştirak etmək inkişafımız üçün çox vacibdir.
Oxşar Xəbərlər
Linklər



 Elm TV
Elm TV
 Foto
Foto
 Video
Video